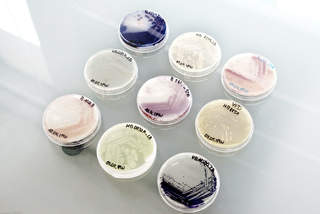

Die Biotechnologie nutzt Mikroorganismen, um Rohstoffe für die Industrie wiederzuverwerten. © BRAIN AG
Die Biologie wirft nichts weg
Herr Eck, was ist industrielle (weiße) Biotechnologie?
Ich möchte das in einem größeren Kontext erklären. Wir kommen aus einer ressourcenverbrauchenden Wirtschaftsform. Unsere Wertschöpfungs- und Stoffverbrauchsketten sind zumeist linear: Sie gehen vom Rohstoff aus und führen zum Endprodukt aber auch zu Abfallprodukten und zum Schluss kommt meistens CO2 heraus. Mit Blick auf die Zukunft erkennen wir, dass wir diesen Ressourcenverbrauch und die Anhäufung von Abfällen nicht mehr hinnehmen können. Die Lösung liegt in einer nachhaltigen Wirtschaftsform, der Bioökonomie. Sie setzt biologische Ressourcen ein und nutzt als technologische Basis den Werkzeugkasten der Natur.
„Wir können viel von der Natur lernen – nicht nur von der Pflanzenwelt.“
Welchen Beitrag kann die Biotechnologie zu einem effizienten Rohstoffkreislauf leisten?
Die Biologie wirft nichts weg. Die Natur verwertet alles, was da ist. In der Natur beobachten wir fast ausschließlich geschlossene Stoffkreisläufe und sogar CO2 wird in den Stoffkreislauf zurückgebracht. Wir können viel von der Natur lernen – nicht nur von der Pflanzenwelt, die wir sehen. Der viel größere Schatz an Syntheseleistung, an Ideen, an Kreativität, wie Stoffe produziert, recycelt und wie Abfälle vermieden werden können, findet sich in der Welt der Mikroorganismen, der Pilze, der Bakterien. Sie existieren seit rund drei Milliarden Jahren und haben über die Zeit gelernt, jeden Stoff zu verwerten und in den Stoffkreislauf zurückzubringen. Die Biotechnologie nutzt genau diese Prinzipien.
Wie nutzt die Biotechnologie diese Prinzipien?
Unser erster Ansatzpunkt ist, bei bestehenden bekannten Produkten von fossilen auf nachwachsende Rohstoffe umzustellen und diese Produktionsprozesse energieeffizienter und nachhaltiger zu machen. Es gibt es mittlerweile viele Basischemikalien wie zum Beispiel Kunststoffe, die wir auf Grundlage nachwachsender Rohstoffe wie Stärke herstellen können. Der zweite Ansatz ist ebenso wichtig: Hier geht es darum, neue Produkte zu entwickeln und diese Produkte in Stoffkreisläufe einzubinden. Die Palette reicht von Grund- und Baustoffen, Textilien bis hin zu Nahrungsmitteln und Kosmetika – alles was Verbraucher aber auch die Industrie heute benötigen.
Hat Biokunststoff aus nachwachsenden Rohstoffen die gleichen Eigenschaften wie herkömmlicher Kunststoff?
Es gibt eine ganze Reihe von Biokunststoffen für verschiedene Einsatzbereiche, die identische Eigenschaften zu den entsprechenden Kunststoffsorten aus fossilen Rohstoffen haben. Selbst Nylon kann mittlerweile mit Enzymen in biotechnologischen Fermentationsverfahren hergestellt werden und ermöglicht so im ersten Schritt die Umstellung auf nachwachsende Rohstoffe. Ein wichtiges Ziel ist jedoch, vor allem für Verpackungsmaterialen und Getränkeflaschen bioabbaubare oder sogar kompostierbare Biokunststoffe zu entwickeln, um die Anhäufung von Plastikmüll und von Mikroplastik in Flüssen und Meeren anzugehen. Die Biotechnologie kann beides: Biokunststoffe die kompostierbar sind und solche, die sehr beständig sind.

Viele Biokunststoffe haben identische Eigenschaften zu Kunstoffen aus fossilen Rohstoffen. © DePho/AdobeStock

Monomere von Bioplastik können in Fermentationsanlagen, in denen Mikroorganismen kultiviert sind, hergestellt werden. © BRAIN AG
Eine andere Herausforderung ist die Rückgewinnung von Edelmetallen und seltenen Erden aus unseren Abfällen. Welche Lösungen gibt es da?
Die Lösung heißt Urban-Mining. Heute gewinnen wir Gold, indem wir ein tiefes Loch graben, nach Goldadern suchen und das Gold mithilfe von harter und zum Teil umweltbelastender Chemie aus dem Gestein lösen. In der Biotechnologie haben wir einen anderen Weg gefunden, Gold zu isolieren. Dabei haben wir uns auf die Stärke von Mikroorganismen besonnen. Diese Bakterien können aus kleingemahlenem Golderz mit nichts anderem als Wasser und etwas Strom zum Rühren des Ansatzes das Gold isolieren. Das funktioniert ganz ohne Chemie und ohne große Umweltbelastungen. Damit haben wir eine alternative Technologie für die großen Goldminen. Es geht aber noch weiter: In einer typischen Goldmine findet man um die vier Gramm Gold pro Tonne Erz. In der Asche von Müllverbrennungsanlagen liegt der Goldgehalt bei einem bis zwei Gramm pro Tonne.
Was passiert damit?
Da die Anwendung von umweltbelastender Chemie bei uns in Deutschland verboten ist, landet dieses Gold mit der Asche meist im Straßenbau. Aktuell verbuddeln wir in Deutschland ungefähr fünf Millionen Tonnen Asche im Jahr und darin befinden sich dann ein bis drei Tonnen Gold. Mit Hilfe von hoch selektiv agierenden Mikroorganismen können wir dagegen auch sehr geringe Mengen Gold, beispielsweise aus der Asche, isolieren und wiedergewinnen. Das heißt, wir können Gold im Gegenwert von 52 Millionen Euro, das bislang in den Straßenbau fließt, im Urban Mining wieder zugänglich machen. Damit kommen wir auch hier weg von der linearen Wertschöpfungskette zu einem ökologisch und ökonomisch sinnvollen Kreislauf. Der funktioniert übrigens auch bei Platin und anderen Metallen wie seltenen Erden. Hier hat die Biotechnologie das Potenzial, die intensive Chemie zu ersetzen.
Funktioniert das auch bei Elektroschrott oder nur bei Asche?
Im Elektroschrott steckt das Gold unter anderem in den Kontakten auf den Leiterplatten. Das gute beim Elektroschrott ist, dass er eine Vielzahl verschiedener hochwertiger Metalle und seltener Erden enthält. Hier ist das Ziel, mit verschiedenen Mikroorganismen möglichst viele der wertvollen Stoffe aus diesem Abfallstrom zurückzugewinnen. Im Labor funktioniert der Prozess, er muss nun zusammen mit industriellen Partnern für größere Anlagen skaliert werden.

Pilotanlage für Urban Mining: Im mobilen Labor können Rohstoffe aus Elektroschott oder Asche zurückgewonnen werden. © BRAIN AG

Dazu kommen spezifische Mikroorganismen zum Einsatz, die Edelmetalle oder Seltene Erden umweltschonend extrahieren. © BRAIN AG
Wo sehen Sie das größte Potenzial für das Urban Mining?
Ökonomisch bringt Urban Mining für Deutschland zum Beispiel den direkten Zugang zu Gold, Platin aber auch zu seltenen Erden. Das macht uns weniger abhängig von den Rohstoffinhabern. Ökologisch wäre es ein Gewinn, wenn wir das chemische Verfahren komplett ersetzen könnten. Wenn wir das biotechnologische Verfahren im großen Stil global im Bergbau einsetzen, wäre das natürlich für beide Aspekte ein riesiger Durchbruch.
Welche Industrien profitieren davon?
Davon profitieren eine ganze Reihe von Industrien – vom Anlagenbau bis hin zur Analytik. Wenn wir in Deutschland anfangen, seltene Erden zu isolieren, entsteht hier eine Industrie, die es derzeit noch gar nicht gibt. Wir beziehen seltene Erden ja vorwiegend aus China. Hinzukommt, dass die benötigten Mikroorganismen ebenfalls produziert werden müssen. Große Chemiekonzerne sehen heute in der industriellen Biotechnologie eine ihrer Wachstumssäulen. Die Transformation ist bereits im Gange. Wichtig ist, dass wir wegkommen vom inkrementellem Ersatzdenken, indem wir den einen durch einen anderen, klimafreundlicheren Stoff ersetzen. Das ist nur halb gesprungen. Komplett springen bedeutet, dass wir gänzlich neue Produkte und Verfahren entwickeln, um unsere Ressourcen optimal zu nutzen und die CO2-Emissionen zu reduzieren. Wir brauchen diesen Wandel auch im Denken – dann werden ganz neue Industrien entstehen.
Die Biotechnologie ist nicht frei von Gefahren. Welche Risiken gibt es dabei?
Die möglichen Risiken werden in der Gesellschaft bereits breit diskutiert. Einer dieser Punkte ist die Verwendung lebender Mikroorganismen, die molekularbiologisch genetisch verändert wurden. Hier muss sichergestellt sein, dass sie sich nicht unkontrolliert in der Natur replizieren. Die Biotechnologie arbeitet meist in geschlossenen Gefäßen. So können wir kontrollieren, was mit den Mikroorganismen passiert. Beim Urban Mining verwenden wir hingegen tote Mikroorganismen. Damit ist dieses Risiko ausgeschlossen. Außerdem: Enzyme können sich nicht selbst vermehren. Waschmittelenzyme etwa, die im Abwasser landen, werden in der Kläranlage so abgebaut wie jedes andere Eiweißmolekül auch.
„Die Biotechnologie wird mit Macht kommen und mit vielen guten Lösungen.“
Wie groß ist der Markt für biotechnologische Verfahren und Produkte?
Dazu gibt es eine Reihe von Studien. Das McKinsey Global Institute (MGI) etwa geht davon aus, dass bis zum Jahr 2040 60 Prozent der physischen Güter der Welt mit biologischen Mitteln erzeugt werden. Dahinter liege in den Jahren von 2030 bis 2040 ein jährliches direktes wirtschaftliches Potenzial von weltweit zwei bis vier Billionen US-Dollar – zuzüglich der indirekten und sekundären Auswirkungen. Das umfasst allerdings auch alle anderen Bereiche der Biotechnologie. Ich bin überzeugt, dass die Biotechnologie mit Macht kommen wird und mit vielen guten Lösungen. In der Vergangenheit waren die Gewinner eines Wirtschaftssystems meist die Inhaber der Rohstoffe. Die Rohstoffe sind der Startpunkt für die lineare Kette. Die Gewinner der neuen Wirtschaftsform werden die Technologieinhaber sein. Ihr Mehrwert ist, dass sie neue Produkte ermöglichen, auf nachwachsende Rohstoffe bauen oder sogar Stoffkreisläufe schließen.
Wo steht Deutschland bei dieser Entwicklung im internationalen Vergleich?
Das Wissen ist vorhanden. Die Unternehmer eigentlich auch. Aber in Deutschland und Europa sind wir einfach zu langsam, wenn es um den Transfer von Wissen in unternehmerisches Tun geht. Hinzukommt das im Vergleich zu den USA unterentwickelte Kapitalmarktsystem in Deutschland. Die Forschung und der Aufbau neuer Unternehmen kosten viel Geld, aber es gibt hierzulande zu wenig Finanzierungsmöglichkeiten, zu wenige Vorteile für mutige Investoren. Mut macht dagegen, dass es inzwischen ein politisches Commitment in Form der nationalen Bioökonomiestrategie gibt. Die Politik hat erkannt, dass wir unsere Klima- und Nachhaltigkeitsziele nur erreichen, wenn wir das große Potenzial der Bioökonomie für uns nutzen.

Dr. Jürgen Eck ist Doktor der Biochemie und begründete 1993 die BRAIN AG mit. Bis 2000 war er Leiter Forschung und Entwicklung, danach CTO des Unternehmens. 2015 bis 2019 agierte er als CEO der BRAIN AG. 2020 gründete er bio.IMPACT. © BRAIN AG